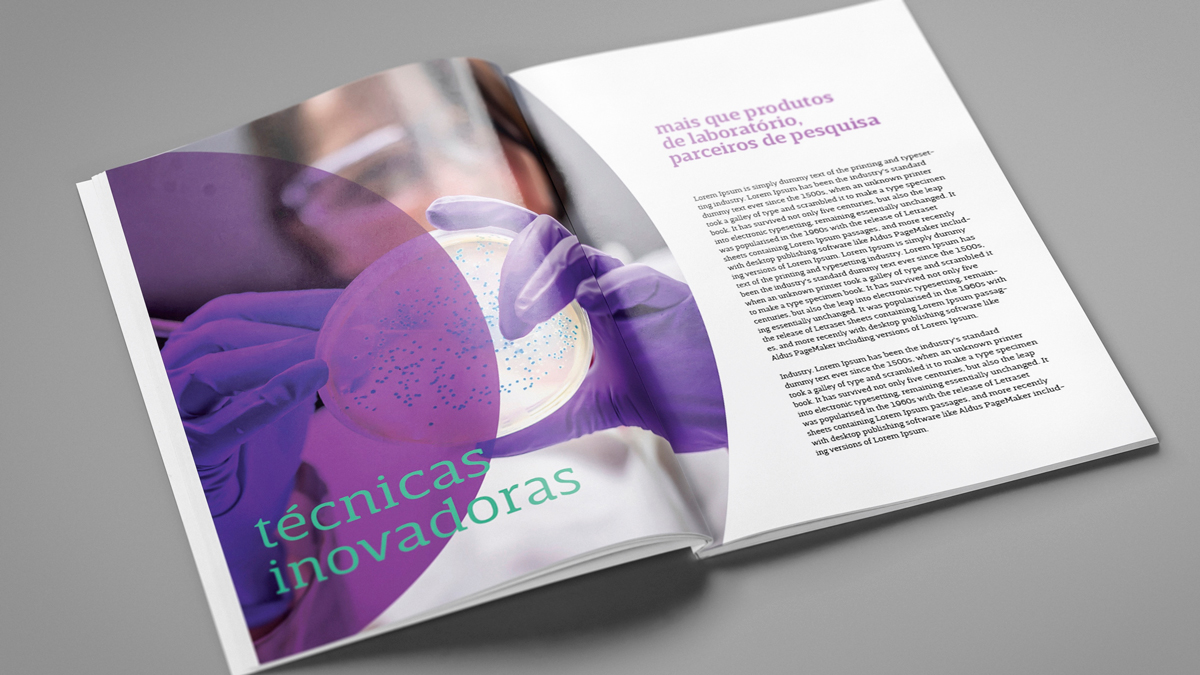

A Plastlabor está de cara nova! E a novidade começa na própria forma de escrever o nome, agora, tudo junto. Trata-se da primeira releitura da marca, criada à época de sua fundação, em 1987. E, se a indústria está às vésperas de ganhar nova casa, na planta de Curicica, o endereço virtual – https://plastlabor.com.br – também ganha nova forma e novo conteúdo.

A nova marca simboliza a evolução da Plastlabor. Originariamente voltada mais à produção de artefatos de plástico, a empresa passou com o tempo a atuar de forma mais significativa no segmento de microbiologia, a partir do desenvolvimento de meios de cultura prontos para uso.

A Plastlabor passou, então, a oferecer um portfólio completo, tanto os meios de cultura, quanto as placas de petri descartáveis, em que são acondicionados e chegam aos clientes. Atualmente, a Plastlabor conta com um portfólio de mais de 500 produtos, e sua equipe de pesquisa e desenvolvimento está permanentemente atenta para criar soluções para necessidades que identifique no mercado.
As duas palavras que compunham o nome da empresa se transformaram em uma, como um nome próprio. O símbolo de apoio, que remete a um P, representa a união entre as ponteiras e alças plásticas – primeiros tempos da empresa – e o meio de cultura pronto e já acondicionado na placa – presente e futuro. A marca tipográfica combina atributos como precisão e contemporaneidade.


